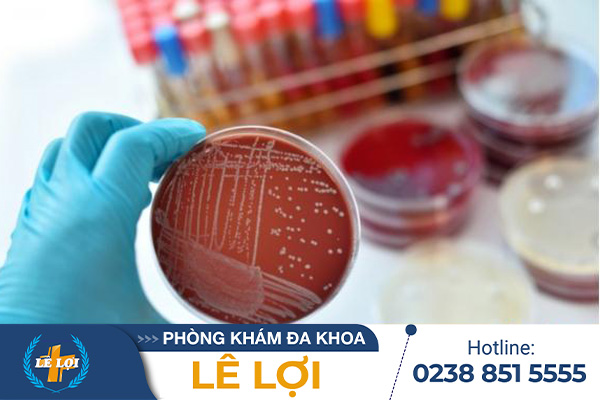

Bệnh lậu gây ra những ảnh hưởng nghiêm trọng đến sức khỏe và cuộc sống. Tuy nhiên không phải ai cũng biết thời gian phát bệnh lậu để kịp thời điều trị. Chính vì thế, bài viết sau sẽ cung cấp những thông tin quan trọng về bệnh lậu, với hi vọng giúp bạn nhanh […]
Lậu là một trong những bệnh truyền nhiễm tình dục nguy hiểm, có tốc độ lây lan nhanh hiện nay. Tuy nhiên, biểu hiện ban đầu có bệnh lậu rất dễ nhầm với các bệnh thông thường khác, nên nhiều người khó nhận ra. Vậy, bệnh lậu có ngứa không? Biểu hiện rõ ràng qua […]
Bệnh lậu là một trong những bệnh xã hội nguy hiểm lây truyền qua đường tình dục không an toàn. Bệnh có thể gây ra các biến chứng tiêu cực cho sức khỏe nếu không được điều trị kịp thời. Việc nắm được các giai đoạn bệnh lậu, tác hại cũng như cách chữa bệnh […]
Lậu thuộc nhóm bệnh xã hội nguy hiểm, lây lan nhanh, nếu không được hỗ trợ điều trị kịp thời và đúng phương pháp sẽ gây nên những biến chứng vô cùng nguy hiểm như ung thư dương vật ở nam giới, ung thư cổ tử cung ở nữ giới. Đặc biệt là khi chuyển […]
Lậu sinh dục là bệnh xã hội phổ biến hiện nay. Mặc dù tỉ lệ người mắc bệnh cao nhưng rất ít người biết được nguyên nhân gây bệnh lậu cũng như dấu hiệu bệnh. Trong bài viết sau chúng tôi sẽ cung cấp cho những thông tin về bệnh lậu sinh dục cũng như […]
Bệnh lậu là tình trạng nhiễm trùng lây truyền qua đường tình dục, có thể xảy ra ở cả nam và nữ giới. Bệnh ảnh hưởng cùng lúc đến nhiều cơ quan khác nhau trong cơ thể, điển hình như: đường sinh dục, họng, trực tràng, khớp… Vậy bạn đã biết dấu hiệu bệnh lậu […]
Bệnh lậu đang không ngừng gia tăng nhanh ở nước ta. Tuy nhiên, việc người bệnh có các thông tin về bệnh lậu còn khá hạn chế. Vậy bệnh lậu là gì? Mức độ nguy hiểm như thế nào? Bệnh lậu chữa bao lâu khỏi? Chúng ta hãy đi tìm câu trả lời qua bài […]
Lậu là căn bệnh xã hội gây ra nhiều hệ lụy nghiêm trọng cho sức khỏe cũng như ảnh hưởng đến tâm lý, sinh hoạt của người bệnh. Xét nghiệm và phát hiện lậu sớm vì thế rất quan trọng để tránh những hậu quả đáng tiếc xảy ra. Bài viết sau đây sẽ mang […]
Bệnh lậu đã và đang khiến cho rất nhiều người hoang mang lo lắng, gây áp lực tâm lý, ảnh hưởng lớn đến khả năng sinh sản, gây xáo trộn cuộc sống hôn nhân. Do đó nắm bắt được biển hiện bệnh lậu là điều rất cần thiết, để chủ động đi khám chữa sớm. […]
Bệnh lậu nguy hiểm không? Thực tế cho thấy, những tác hại bệnh lậu không chỉ ảnh hưởng đến sức khỏe, tâm lý người bệnh mà còn có nguy cơ lây lan rộng ra cộng đồng xã hội. Rất nhiều trường hợp khi phát hiện bản thân mắc bệnh lậu không dám đi khám chữa […]